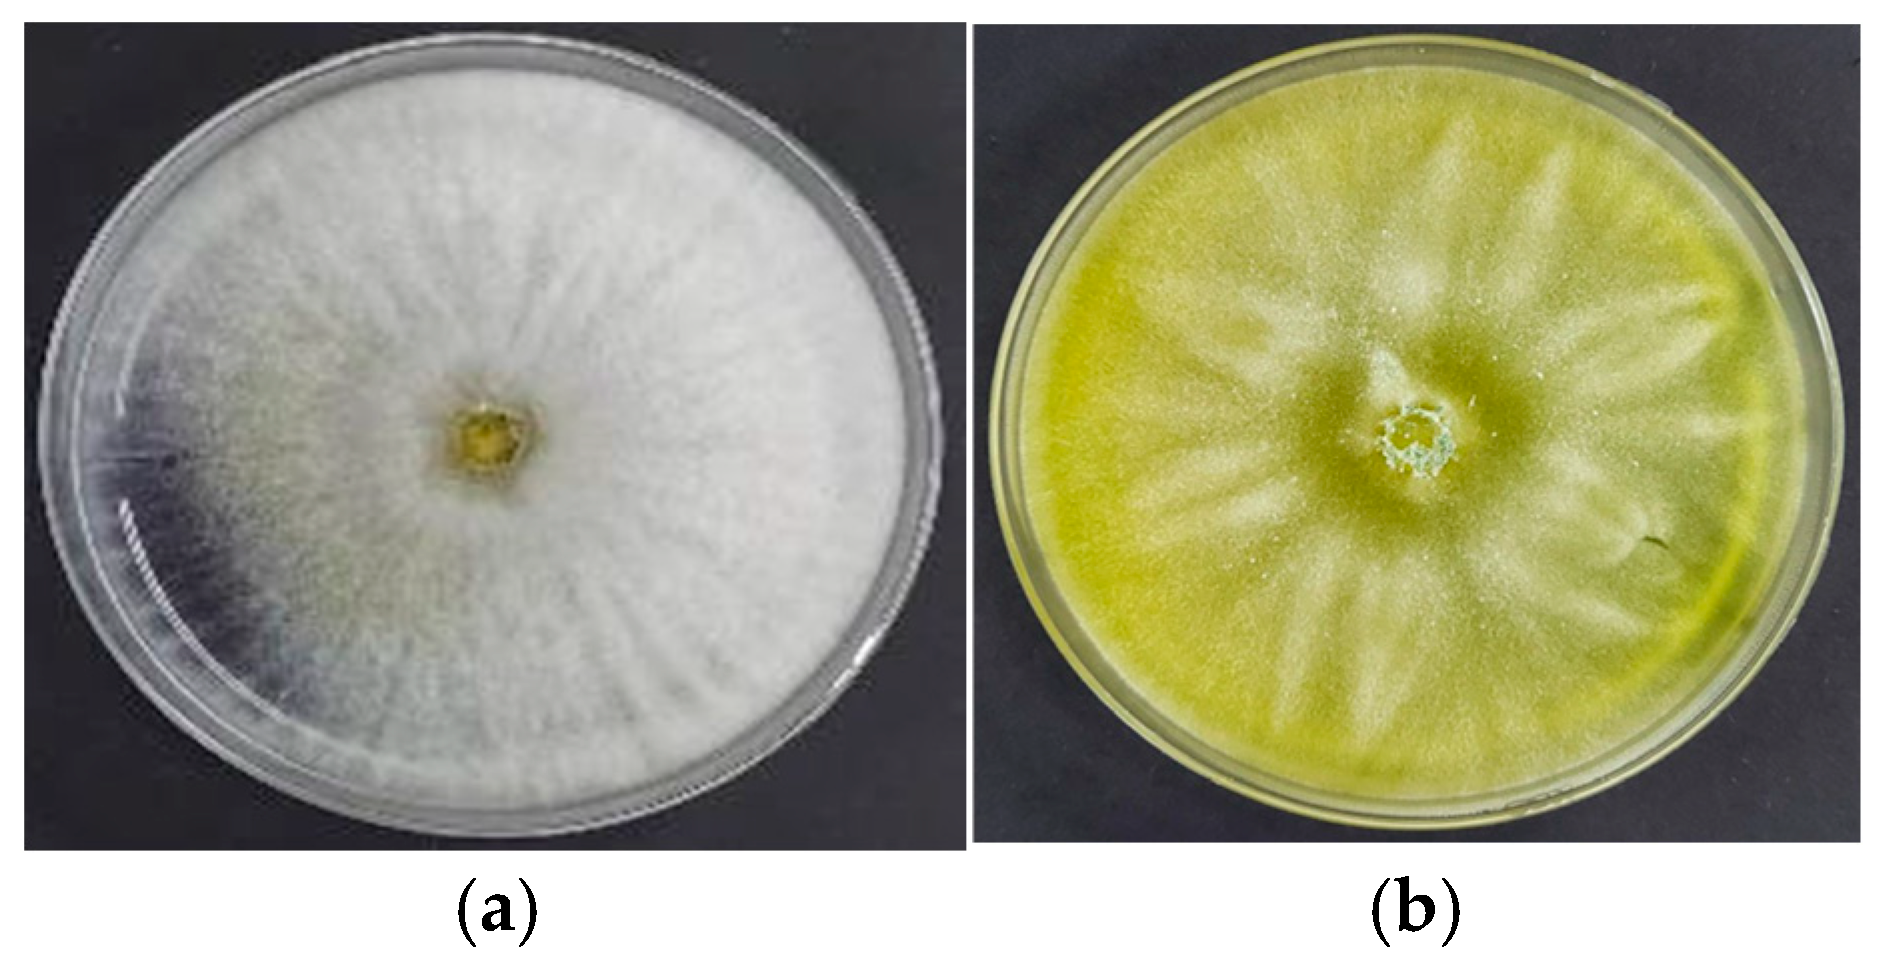
Ijpb 16 00085 g001
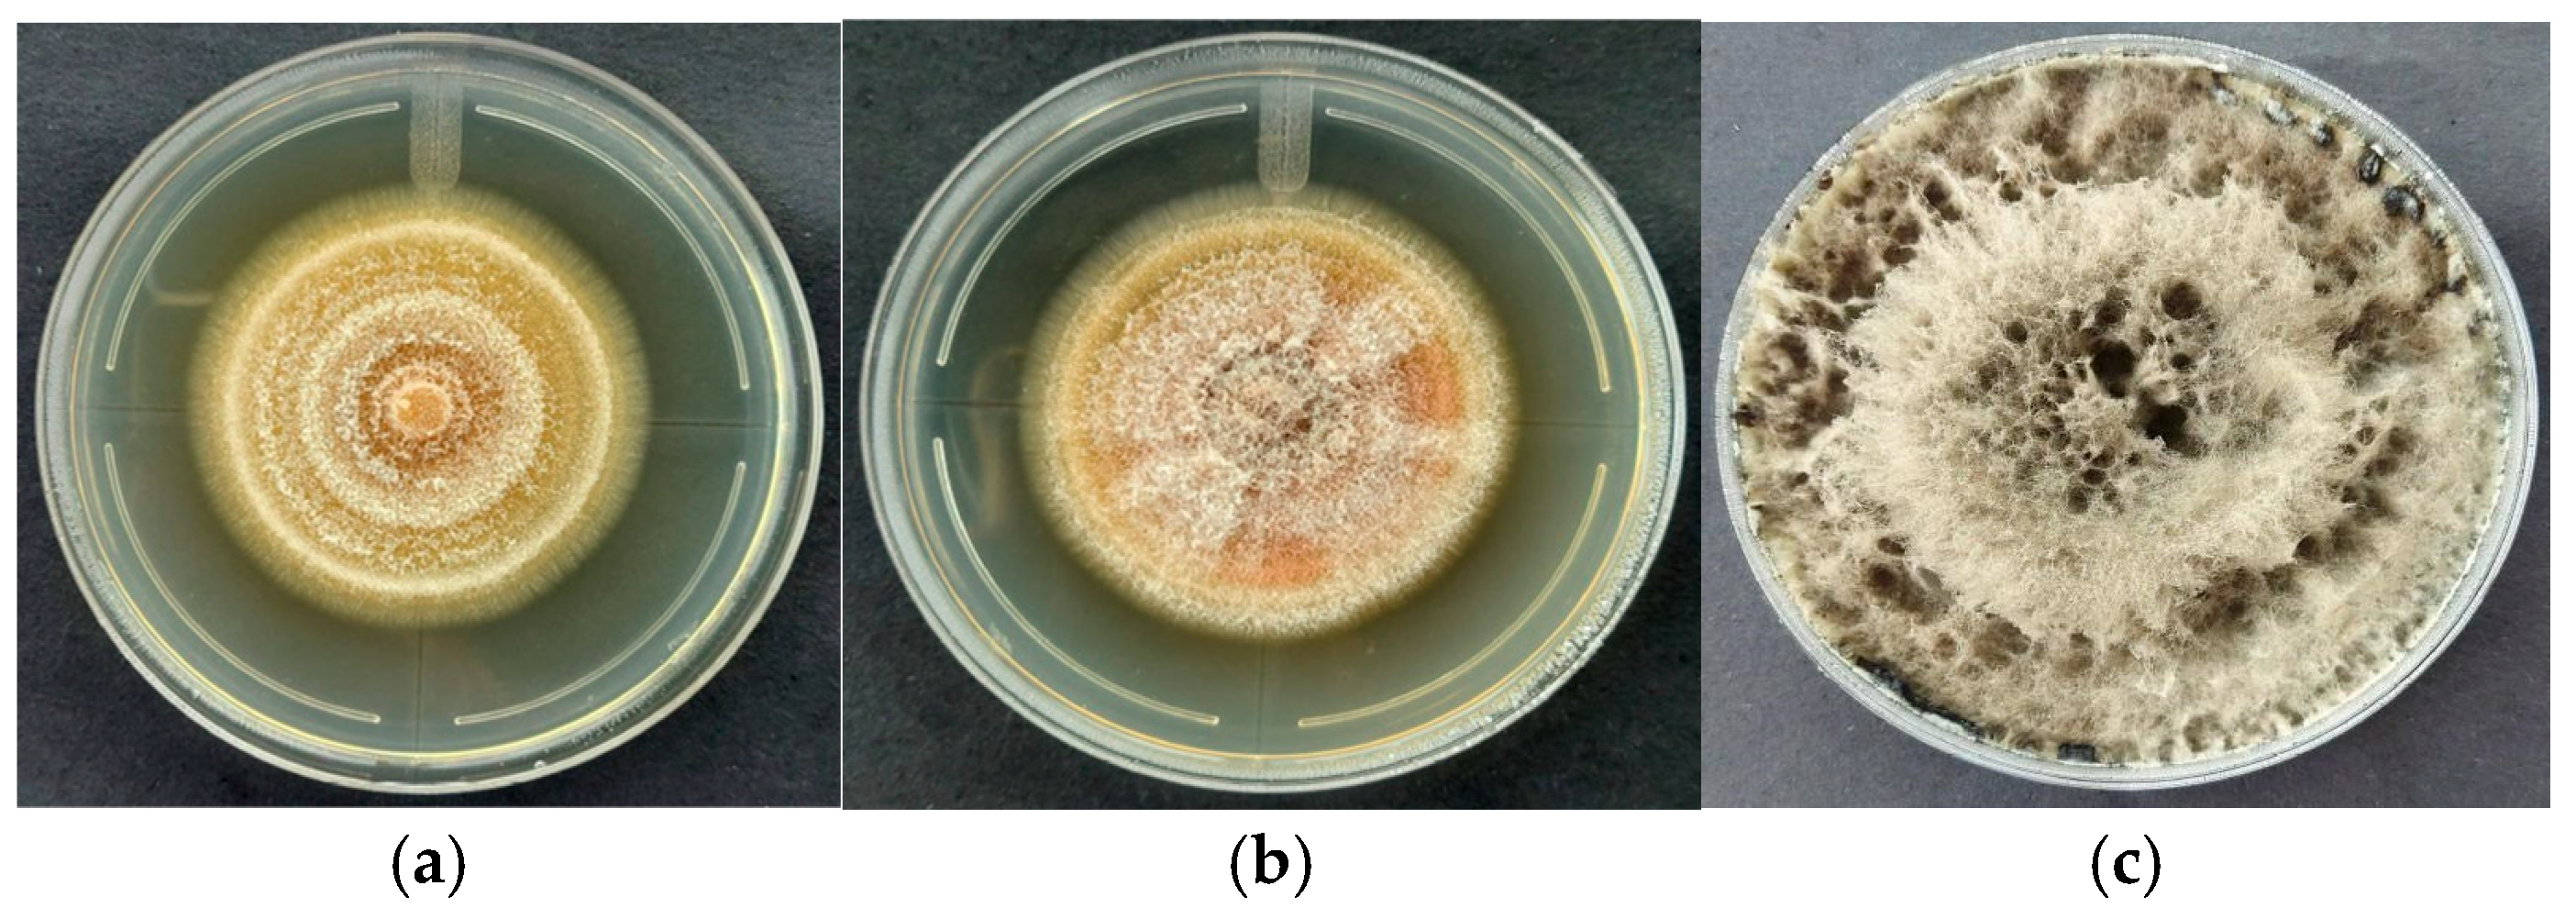
Ijpb 16 00085 g002
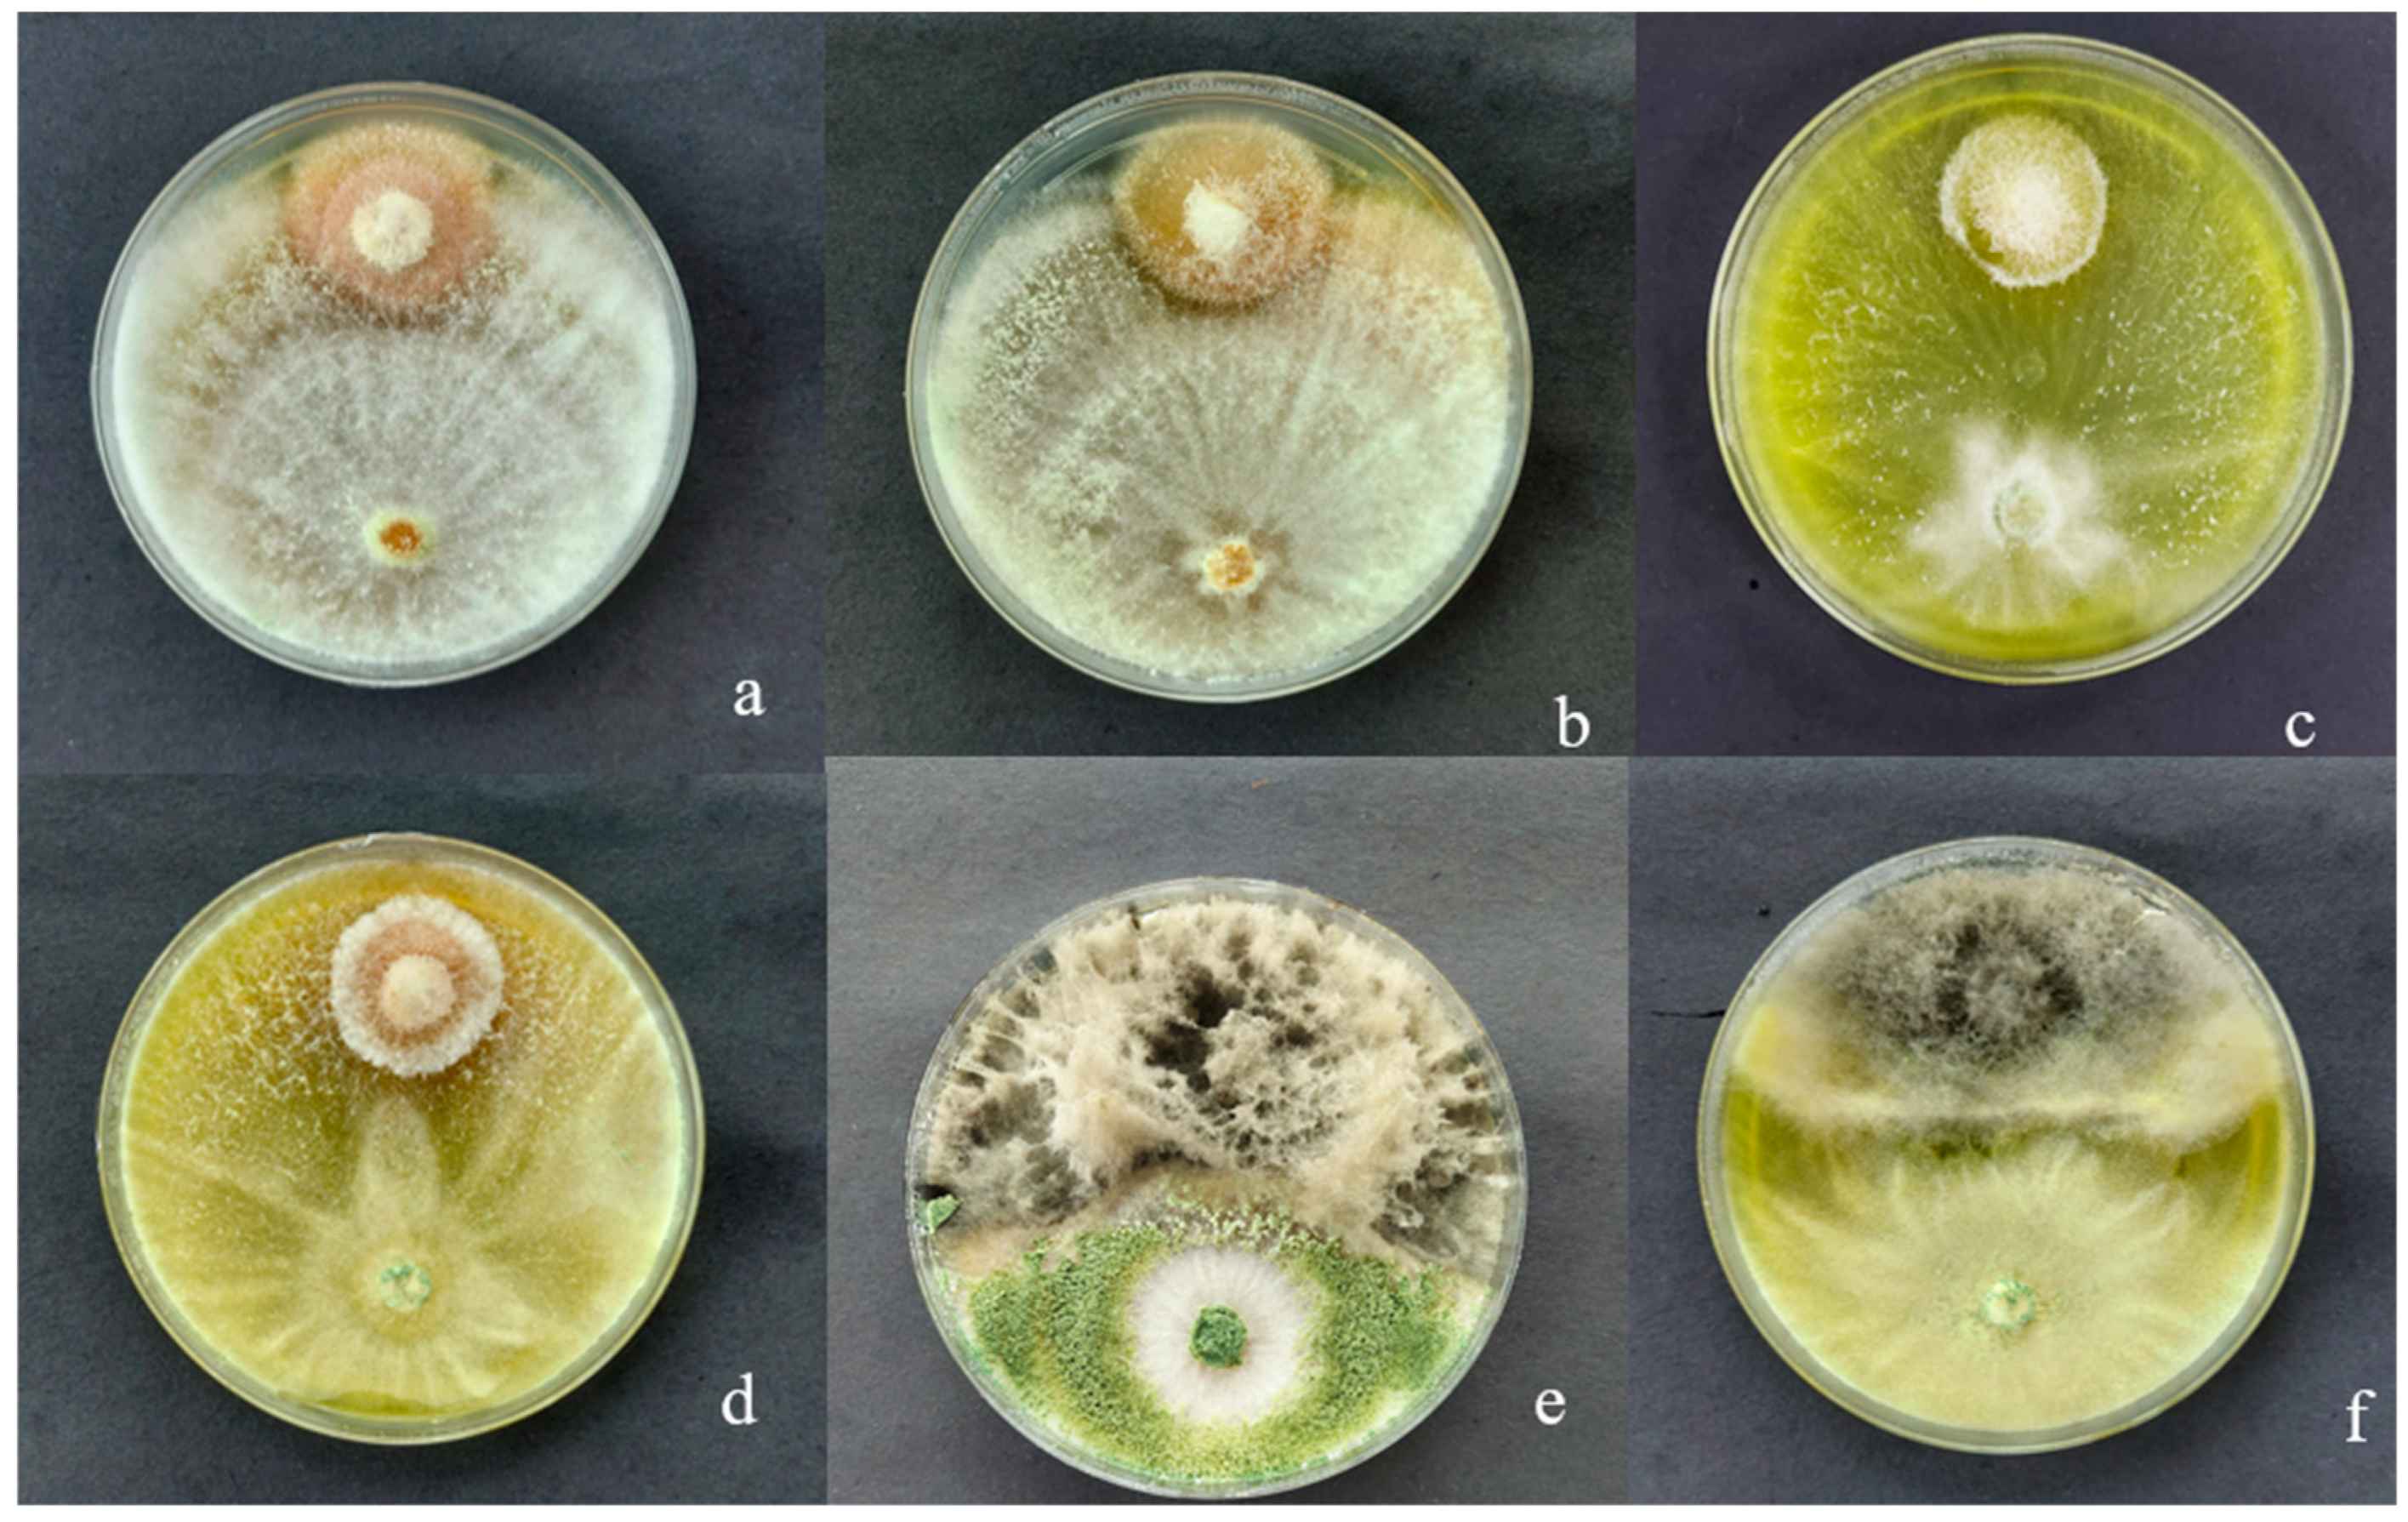
Ijpb 16 00085 g007

In Vitro Antagonism of Two Isolates of the Genus Trichoderma on Fusarium and Botryodiplodia sp., Pathogenic Fungi of Schizolobium parahyba in Ecuador
Abstract
1. Introduction
2. Materials and Methods
2.1. Experimental Site and Conditions
2.2. Experimental Design
2.3. Activation of Trichoderma spp. Isolates and Phytopathogenic Fungi
2.4. Temperature Effects on the Growth of Trichoderma spp. Isolates
2.5. In Vitro Antagonistic Capacity of Trichoderma spp. Isolates
2.6. Microscopic Analysis and Antagonism Scoring
2.7. Statistical Analysis
3. Results
3.1. Macroscopic Characteristics of Trichoderma sp. CEP-01, CEP-02 and S. Parahyba Phytopathogens
3.2. Effect of Incubation Temperature on Trichoderma sp. CEP-01 and Trichoderma sp. CEP-02 Growth Rates
3.3. In Vitro Antagonistic Capacity of Native Trichoderma spp. CEP-01 and CEP-02 Isolates Against Phytopathogenic Fungi of S. parahyba
3.4. Mycoparasitism of Trichoderma spp. on S. parahyba Phytopathogens
4. Discussion
5. Conclusions
Author Contributions
Funding
Data Availability Statement
Acknowledgments
Conflicts of Interest
References
- Ferreira, N.C.d.F.; Gatto, A.; Ramos, M.L.G. Co-Inoculation of Trichoderma harzianum and Bradyrhizobium species Augment the Growth of Schizolobium parahyba var. parahyba (Vell.) Blake Seedlings. Microorganisms 2025, 13, 630. [Google Scholar] [CrossRef]
- Belezaca-Pinargote, C.; Morales-Escobar, C.K.; Solano-Apuntes, E.; López-Tobar, R.; Díaz-Navarrete, P. “Decay and Descending Death” New disease of Schizolobium parahybum (Vell.) S.F. Blake (pachaco) in Ecuador. Int. J. Health Sci. 2022, 6, 14269–14281. [Google Scholar] [CrossRef]
- Camacho, M.E.; Tatis, H.A.; Ayala, C.C. Morphological characteristics and seed viability of Schizolobium parahyba (Vell.) S.F. Blake. Rev. U.D.C.A Actual. Divulg. Cient. 2020, 23, e1530. [Google Scholar] [CrossRef]
- Cely, M.V.T.; Siviero, M.A.; Emiliano, J.; Spago, F.R.; Freitas, V.F.; Barazetti, A.R.; Goya, E.T.; Lamberti, G.D.S.; Dos Santos, I.M.O.; De Oliveira, A.G.; et al. Inoculation of Schizolobium parahyba with mycorrhizal fungi and plant growth-promoting rhizobacteria increases wood yield under field conditions. Front. Plant Sci. 2016, 7, 1708. [Google Scholar] [CrossRef]
- Belezaca Pinargote, C.; Suárez Capello, C.; Vera Coello, D. Hongos fitopatógenos asociados a la enfermedad de muerte regresiva y pudrición del fuste de pachaco (Schizolobium parahybum) en el trópico húmedo ecuatoriano (Fungi pathogens associated with dieback and stem rot disease of pachaco [Schizolobium parahybum] in the Ecuadorian humid tropics). Boletín Micológico 2011, 26, 15–22. [Google Scholar]
- Shennan-Farpón, Y.; Mills, M.; Souza, A.; Homewood, K. The role of agroforestry in restoring brazil’s atlantic forest: Opportunities and challenges for smallholder farmers. People Nat. 2022, 4, 462–480. [Google Scholar] [CrossRef]
- Angelotti, F.; Hamada, E.; Bettiol, W.A. Comprehensive review of climate change and plant diseases in Brazil. Plants 2024, 13, 2447. [Google Scholar] [CrossRef]
- Spies, C.F.J.; Mostert, L.; Carlucci, A.; Moyo, P.; van Jaarsveld, W.J.; du Plessis, I.L.; van Dyk, M.; Halleen, F. Dieback and decline pathogens of olive trees in south Africa. Persoonia Mol. Phylogeny Evol. Fungi 2020, 45, 196–220. [Google Scholar] [CrossRef] [PubMed]
- Pirttilä, A.M.; Tabas, H.M.P.; Baruah, N.; Koskimäki, J.J. Biofertilizers and biocontrol agents for agriculture: How to identify and develop new potent microbial strains and traits. Microorganisms 2021, 9, 817. [Google Scholar] [CrossRef]
- Khazaal, F.A.K.; Ameen, M.K.M.; Ali, A.H. Pathogenic fungi a companied with sudden decline syndrome (wilting disease) of date palm tree (Phoenix dactylifera L.). Basrah J. Sci. 2019, 397, 376. [Google Scholar]
- Pimentel, M.F.; Arnão, E.; Warner, A.J.; Subedi, A.; Rocha, L.F.; Srour, A.; Bond, J.P.; Fakhoury, A.M. Trichoderma isolates inhibit Fusarium virguliforme growth, reduce root rot, and induce defense-related genes on soybean seedlings. Plant Dis. 2020, 104, 1949–1959. [Google Scholar] [CrossRef]
- Gachango, E.; Hanson, L.E.; Rojas, A.; Hao, J.J.; Kirk, W.W. Fusarium spp. causing dry rot of seed potato tubers in michigan and their sensitivity to fungicides. Plant Dis. 2012, 96, 1767–1774. [Google Scholar] [CrossRef]
- Correa-Delgado, R.; Brito-López, P.; Cardoza, R.E.; Jaizme Vega, M.C.; Laich, F.; Gutiérrez, S. Biocontrol potential of a native Trichoderma collection against Fusarium oxysporum f. sp. cubense subtropical race 4. Agriculture 2024, 14, 2016. [Google Scholar] [CrossRef]
- Lee, J.H.; Kim, N.K.; Shin, K.; Lee, J.K.; Lee, D.-H. Preliminary report of three entomopathogenic fungi as potential biocontrol agents against the oak wilt vector, Platypus koryoensis. Forests 2025, 16, 1009. [Google Scholar] [CrossRef]
- Langa-Lomba, N.; Martín-Ramos, P.; Casanova-Gascón, J.; Julián-Lagunas, C.; González-García, V. Potential of native Trichoderma strains as antagonists for the control of fungal wood pathologies in young grapevine plants. Agronomy 2022, 12, 336. [Google Scholar] [CrossRef]
- Vega, D.; Ibarra, S.; Varela Pardo, R.A.; Poggio, S.L. Agroecological management of crop diseases: A review. Agroecol. Sustain. Food Syst. 2023, 47, 919–949. [Google Scholar] [CrossRef]
- Broberg, M.; Dubey, M.; Iqbal, M.; Gudmundssson, M.; Ihrmark, K.; Schroers, H.J.; Funck Jensen, D.; Brandström Durling, M.; Karlsson, M. Comparative genomics highlights the importance of drug efflux transporters during evolution of mycoparasitism in clonostachys subgenus bionectria (fungi, ascomycota, hypocreales). Evol. Appl. 2021, 14, 476–497. [Google Scholar] [CrossRef]
- Varela-Pardo, R.A.; López-Lastra, C.C.; Manfrino, R.G.; Balcazar, D.; Mónaco, C.; Wright, E.R. Selection of fungal isolates from Buenos Aires, Argentina, as biological control agents of Botrytis cinerea and Sclerotinia sclerotiorum. Rev. La Fac. Cienc. Agrar. UNCuyo 2024, 56, 72–86. [Google Scholar] [CrossRef]
- Mukhopadhyay, R.; Kumar, D. Trichoderma: A beneficial antifungal agent and insights into its mechanism of biocontrol potential. Egypt. J. Biol. Pest Control 2020, 30, 133. [Google Scholar] [CrossRef]
- Prismantoro, D.; Chua, K.O.; Teo, K.W.E.; Chan, R.; Jefferson, T.A.; Suhaimi, N.S.M.; Mispan, M.S.; Miranti, M.; Doni, F. Whole genome sequence data of Trichoderma yunnanense strain tm10, a plant growth-promoting fungus and biocontrol agent. Data Brief 2025, 58, 111283. [Google Scholar] [CrossRef]
- Khan, R.A.A.; Najeeb, S.; Hussain, S.; Xie, B.; Li, Y. Bioactive secondary metabolites from Trichoderma spp. against phytopathogenic fungi. Microorganisms 2020, 8, 817. [Google Scholar] [CrossRef]
- Andrés, P.A.; Alejandra, P.M.; Benedicto, M.C.; Nahuel, R.I.; Clara, B.M. A Comparative study of different strains of Trichoderma under different conditions of temperature and pH for the control of Rhizoctonia solani. Agric. Sci. 2022, 13, 702–714. [Google Scholar] [CrossRef]
- Abbas, A.; Mubeen, M.; Zheng, H.; Sohail, M.A.; Shakeel, Q.; Solanki, M.K.; Iftikhar, Y.; Sharma, S.; Kashyap, B.K.; Hussain, S.; et al. Trichoderma spp. genes involved in the biocontrol activity against Rhizoctonia solani. Front. Microbiol. 2022, 13, 884469. [Google Scholar] [CrossRef] [PubMed]
- Kalimutu, P.K.; Komang Mahardika, I.B.; Anak Agung Sagung, P.R.A. Antagonism test of Trichoderma atroviride and Gliocladium sp. bali local isolates as a disease control of blendok disease (Botryodiplodia theobromae) in Grapefruit (Citrus grandis L. Osbeck). SEAS (Sustain. Environ. Agric. Sci.) 2020, 4, 102–110. [Google Scholar] [CrossRef]
- Mesa Vanegas, A.M.; Marín Pavas, D.A.; Calle Osorno, J. Metabolitos secundarios en Trichoderma spp. y sus aplicaciones biotecnológicas agrícolas. Actual. Biológicas 2020, 41, 1–13. [Google Scholar] [CrossRef]
- Rubayet, M.T.; Hossain, M.M. Bio-exploration of plant growth-promoting fungus Trichoderma as a potent candidate for plant disease management: An overview. Online J. Biol. Sci. 2025, 25, 22–52. [Google Scholar] [CrossRef]
- Rees, H.J.; Drakulic, J.; Cromey, M.G.; Bailey, A.M.; Foster, G.D. Endophytic Trichoderma spp. can protect strawberry and privet plants from infection by the fungus armillaria mellea. PLoS ONE 2022, 17, e0271622. [Google Scholar] [CrossRef]
- Kubicek, C.P.; Herrera-Estrella, A.; Seidl-Seiboth, V.; Martinez, D.A.; Druzhinina, I.S.; Thon, M.; Zeilinger, S.; Casas-Flores, S.; Horwitz, B.A.; Mukherjee, P.K.; et al. Comparative genome sequence analysis underscores mycoparasitism as the ancestral life style of Trichoderma. Genome Biol. 2011, 12, R40. [Google Scholar] [CrossRef]
- Pratap Singh, S.; Keswani, C.; Pratap Singh, S.; Sansinenea, E.; Xuan Hoat, T. Trichoderma spp. mediated induction of systemic defense response in brinjal against Sclerotinia sclerotiorum. Curr. Res. Microb. Sci. 2021, 2, 100051. [Google Scholar] [CrossRef]
- Bai, B.; Liu, C.; Zhang, C.; He, X.; Wang, H.; Peng, W.; Zheng, C. Trichoderma species from plant and soil: An excellent resource for biosynthesis of terpenoids with versatile bioactivities. J. Adv. Res. 2023, 49, 81–102. [Google Scholar] [CrossRef]
- Valenzuela, R.V.; Gálvez, G.T.; Villa, R.; Eber, D.; Parra, C.; Fannie, I.; Santoyo, G.; Santos-Villalobos, S. Lipopeptides produced by biological control agents of the genus Bacillus: A review of analytical tools used for their study. Rev. Mex. Cienc. Agrícolas 2020, 11, 419–432. [Google Scholar] [CrossRef]
- Joo, J.H.; Hussein, K.A. Biological control and plant growth promotion properties of volatile organic compound-producing antagonistic Trichoderma spp. Front. Plant Sci. 2022, 13, 897668. [Google Scholar] [CrossRef]
- Sahlan, F.K.; Rusicha, F.A.; Darmawan, A.A. Isolation and antagonistic test of fungi associated with pummelo citrus against Botryodiplodia theobromae in vitro. IOP Conf. Ser. Earth Environ. Sci. 2023, 1230, 012110. [Google Scholar] [CrossRef]
- Rondoy, M.G.; Severino, N.V. Antagonistic capacity of Trichoderma harzianum compared to rhizotecnia, Nakataea sigmoidea, Sclerotium rolfsii and its effect in native strains of Trichoderma isolated form rice crops. Sci. Agropecu. 2019, 10, 199–206. [Google Scholar] [CrossRef]
- Asghar, W.; Craven, K.; Kataoka, R.; Mahmood, A.; Asghar, N.; Raza, T.; Iftikhar, F. The application of Trichoderma spp., an old but new useful fungus, in sustainable soil health intensification: A comprehensive strategy for addressing challenges. Plant Stress 2024, 12, 100455. [Google Scholar] [CrossRef]
- Viterbo, A.; Harel, M.; Horwitz, B.A.; Chet, I.; Mukherjee, P.K. Trichoderma mitogen-activated protein kinase signaling is involved in induction of plant systemic resistance. Appl. Environ. Microbiol. 2005, 71, 6241–6246. [Google Scholar] [CrossRef]
- Rubio-Sosa, A.; Martínez-Bolaños, M.; Gómez-Leyva, J.F.; Lozano-Trejo, S.; Castañeda-Hidalgo, E.; Diaz-Zorrilla, G.O. Inhibition of Colletotrichum spp. causing Anthracnose in Coffee (Coffea Arabica) using native isolates of Trichoderma sp. Mex. J. Phytopathol. 2025, 43, 58. [Google Scholar] [CrossRef]
- Khuong, N.Q.; Nhien, D.B.; Thu, L.T.M.; Trong, N.D.; Hiep, P.C.; Thuan, V.M.; Quang, L.T.; Thuc, L.V.; Xuan, D.T. Using Trichoderma asperellum to Antagonize Lasiodiplodia theobromae Causing Stem-End Rot Disease on Pomelo (Citrus maxima). J. Fungi. 2023, 9, 981. [Google Scholar] [CrossRef] [PubMed]
- Domingues, M.V.; de Moura, K.E.; Salomão, D.; Elias, L.M.; Patricio, F.R.A. Efeito da temperatura sobre o crescimento micelial de Trichoderma, Sclerotinia Minor e S. Sclerotiorum e Sobre o Micoparasitismo. Summa Phytopathol. 2016, 42, 222–227. [Google Scholar] [CrossRef]
- Rodríguez-García, D.; Vargas-Rojas, J. Efecto de la inoculación con Trichoderma sobre el crecimiento vegetativo del tomate (Solanum lycopersicum). Agron. Costarric. 2022, 46, 47. [Google Scholar] [CrossRef]
- Wesener, F.; Rillig, M.C.; Tietjen, B. Heat stress can change the competitive outcome between fungi: Insights from a modelling approach. Oikos 2023, 2023, e09377. [Google Scholar] [CrossRef]
- Alwadai, A.S.; Perveen, K.; Alwahaibi, M. The isolation and characterization of antagonist Trichoderma spp. from the soil of abha, Saudi Arabia. Molecules 2022, 27, 2525. [Google Scholar] [CrossRef]
- Del Carmen López-Ferrer, U.; Brito-Vega, H.; López-Morales, D.; Salaya-Domínguez, J.M.; Gómez-Méndez, E. Papel de Trichoderma en los sistemas agroforestales-cacaotal como un agente antagónico. Trop. Subtrop. Agroecosystems 2017, 20, 91–100. [Google Scholar] [CrossRef]
- Gerardo Leyva-Mir, S.; Errol Vega-Portillo, H.; Eduardo Villaseñor-Mir, H.; Tlapal-Bolaños, B.; Vargas-Hernández, M.; Camacho-Tapia, M.; Manuel Tovar-Pedraza, J. Characterization of Fusarium species causing root rot of wheat in the bajio, Mexico. Anim. Sci. Agro-Cienc. 2017, 33, 142–151. [Google Scholar]
- Khuong, N.Q.; Thuy Trang, C.T.; Xuan, D.T.; Quang, L.T.; Huu, T.N.; Thanh Xuan, L.N.; Sakagami, J.I.; Thuc, L.V. Evaluation of the antagonistic potential of Trichoderma spp. against Fusarium oxysporum F.28.1A. J. Plant Prot. Res. 2023, 63, 13–26. [Google Scholar] [CrossRef]
- Ahimera, N.; Gisler, S.; Morgan, D.P.; Michailides, T.J. Effects of Single-Drop impactions and natural and simulated rains on the dispersal of Botryosphaeria dothidea conidia. Phytopathology 2004, 94, 1189–1197. [Google Scholar] [CrossRef]
- Jami, F.; Wingfield, M.J.; Gryzenhout, M.; Slippers, B. Diversity of tree-infecting Botryosphaeriales on native and non-native trees in South Africa and Namibia, Australasian. Plant Pathol. 2017, 46, 529–545. [Google Scholar]
- Firmansyah, M.A.; Jayanegara, A.; Ria, M.; Solaya, G.; Ikhwan, D.; Syifaudin, S. The effect of essential oils of Citronella and Patchouli oil on growth of Botryodiplodia sp. in vitro. J. Trop. Silvic. 2023, 14, 39–46. [Google Scholar] [CrossRef]
- Pawar, V.P. Impact of ecological factors on development of Botryodiplodia rot of guava fruit. Curr. Bot. 2012, 3, 16. [Google Scholar]
- Nazar Pour, F.; Ferreira, V.; Félix, C.; Serôdio, J.; Alves, A.; Duarte, A.S.; Esteves, A.C. Effect of temperature on the phytotoxicity and cytotoxicity of Botryosphaeriaceae fungi. Fungal Biol. 2020, 124, 571–578. [Google Scholar] [CrossRef] [PubMed]
- Ruiz-Valencia, J.A.; Vázquez-Sánchez, M.; Burgos-Hernández, M.; Gutiérrez, J.; Terrazas, T. Wood anatomy of Forestiera (oleaceae) species in Mexico. Acta Bot. Mex. 2021, 128, 1–17. [Google Scholar] [CrossRef]
- Daryaei, A.; Jones, E.E.; Ghazalibiglar, H.; Glare, T.R.; Falloon, R.E. Effects of temperature, light and incubation period on production, germination and bioactivity of Trichoderma atroviride. J. Appl. Microbiol. 2016, 120, 999–1009. [Google Scholar] [CrossRef] [PubMed]

| Treatments | Description |
|---|---|
| 1 | Trichoderma sp. CEP-01 5 ± 2 °C |
| 2 | Trichoderma sp. CEP-01 24 ± 2 °C |
| 3 | Trichoderma sp. CEP-01 30 ± 2 °C |
| 4 | Trichoderma sp. CEP-02 5 ± 2 °C |
| 5 | Trichoderma sp. CEP-02 24 ± 2 °C |
| 6 | Trichoderma sp. CEP-02 30 ± 2 °C |
| Grado | Antagonistic Capacity |
|---|---|
| 1 | Trichoderma fully colonizes the medium and overgrows the phytopathogen. |
| 2 | Trichoderma colonizes two-thirds of the medium and restricts pathogen growth. |
| 3 | Trichoderma and the phytopathogen each colonize half of the medium, with no dominance. |
| 4 | The phytopathogen colonizes two-thirds of the medium and restricts Trichoderma growth. |
| 5 | The phytopathogen completely dominates and inhibits Trichoderma growth. |
| Treatments | Interactions |
|---|---|
| 1 | CEP-01 v/s. FE07 |
| 2 | CEP-01 v/s FE08 |
| 3 | CEP-01 v/s BIOT |
| 4 | CEP-02 v/s FE07 |
| 5 | CEP-02 v/s FE08 |
| 6 | CEP-02 v/s BIOT |
| 7 | CEP-01 and CEP-02 v/s FE07 |
| 8 | CEP-01 and CEP-02 v/s FE08 |
| 9 | CEP-01 and CEP-02 v/s BIOT |
| 10 | BIOT FE07 control |
| 11 | FE08 control |
| 12 | BIOT control |
Disclaimer/Publisher’s Note: The statements, opinions and data contained in all publications are solely those of the individual author(s) and contributor(s) and not of MDPI and/or the editor(s). MDPI and/or the editor(s) disclaim responsibility for any injury to people or property resulting from any ideas, methods, instructions or products referred to in the content. |
© 2025 by the authors. Licensee MDPI, Basel, Switzerland. This article is an open access article distributed under the terms and conditions of the Creative Commons Attribution (CC BY) license (https://creativecommons.org/licenses/by/4.0/).
Share and Cite
Belezaca-Pinargote, C.; Intriago-Pinargote, B.; Belezaca-Pinargote, B.; Solano-Apuntes, E.; Varela-Pardo, R.A.; Díaz-Navarrete, P. In Vitro Antagonism of Two Isolates of the Genus Trichoderma on Fusarium and Botryodiplodia sp., Pathogenic Fungi of Schizolobium parahyba in Ecuador. Int. J. Plant Biol. 2025, 16, 85. https://doi.org/10.3390/ijpb16030085
Belezaca-Pinargote C, Intriago-Pinargote B, Belezaca-Pinargote B, Solano-Apuntes E, Varela-Pardo RA, Díaz-Navarrete P. In Vitro Antagonism of Two Isolates of the Genus Trichoderma on Fusarium and Botryodiplodia sp., Pathogenic Fungi of Schizolobium parahyba in Ecuador. International Journal of Plant Biology. 2025; 16(3):85. https://doi.org/10.3390/ijpb16030085
Chicago/Turabian StyleBelezaca-Pinargote, Carlos, Bélgica Intriago-Pinargote, Brithany Belezaca-Pinargote, Edison Solano-Apuntes, Ricardo Arturo Varela-Pardo, and Paola Díaz-Navarrete. 2025. "In Vitro Antagonism of Two Isolates of the Genus Trichoderma on Fusarium and Botryodiplodia sp., Pathogenic Fungi of Schizolobium parahyba in Ecuador" International Journal of Plant Biology 16, no. 3: 85. https://doi.org/10.3390/ijpb16030085
APA StyleBelezaca-Pinargote, C., Intriago-Pinargote, B., Belezaca-Pinargote, B., Solano-Apuntes, E., Varela-Pardo, R. A., & Díaz-Navarrete, P. (2025). In Vitro Antagonism of Two Isolates of the Genus Trichoderma on Fusarium and Botryodiplodia sp., Pathogenic Fungi of Schizolobium parahyba in Ecuador. International Journal of Plant Biology, 16(3), 85. https://doi.org/10.3390/ijpb16030085

